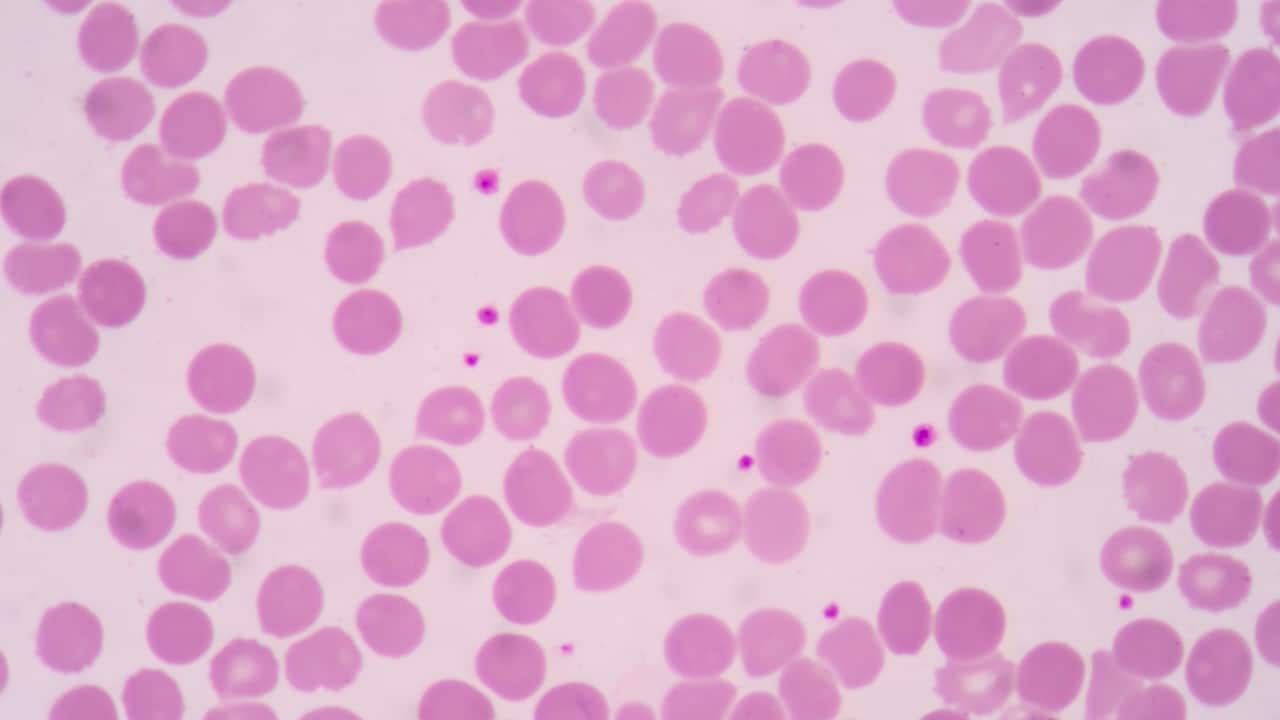
Dengue fever can lead to a decrease in platelet count, which is a concern because low platelets (thrombocytopenia) can increase the risk of bleeding. While medical treatment is essential, certain natural approaches may help support platelet count recovery. Always consult with a healthcare provider before trying new remedies, especially in the context of a serious illness like dengue. Dr Sapna Rana from RKG Healthcare Hospital, Pune, suggests eight natural ways that might help increase platelet count. (Image: Canva)

Cure for dengue fever: Increase your platelet count with these 8 foods in your daily diet
Dengue is prevalent in tropical and subtropical regions, making it a major public health concern in many parts of the world. Dengue fever can lead to a decrease in platelet count, which is a concern because low platelets can increase the risk of bleeding. Here are 8 foods that you can consider to increase your platelet count.
1/10

Dengue fever is a viral illness transmitted by Aedes mosquitoes, particularly Aedes aegypti. It is characterised by a sudden high fever, severe headache, pain behind the eyes, joint and muscle pain, and rash, dengue fever can range from mild to severe. In its more severe forms, such as dengue hemorrhagic fever or dengue shock syndrome, it can lead to significant complications, including bleeding, plasma leakage, and shock. Dengue is prevalent in tropical and subtropical regions, making it a major public health concern in many parts of the world. (Image: Canva)
2/10
Dengue fever can lead to a decrease in platelet count, which is a concern because low platelets (thrombocytopenia) can increase the risk of bleeding. While medical treatment is essential, certain natural approaches may help support platelet count recovery. Always consult with a healthcare provider before trying new remedies, especially in the context of a serious illness like dengue. Dr Sapna Rana from RKG Healthcare Hospital, Pune, suggests eight natural ways that might help increase platelet count. (Image: Canva)
3/10

Papaya leaf juice: Papaya leaf juice is believed to help increase platelet count and improve overall blood health. Extract the juice from fresh papaya leaves and consume a small amount daily. Consult with a doctor for an appropriate dosage. (Image: Canva)
4/10

Pomegranate juice: Pomegranate is rich in iron and vitamins that support blood health. Drink fresh pomegranate juice daily to help boost platelet levels. (Image: Canva)
5/10

Beetroot: Beetroot is rich in essential nutrients like iron, which supports red blood cell production. Consume fresh beetroot juice or include beetroot in your diet. (Image: Canva)
6/10

Spinach: Spinach contains vitamins and minerals that promote healthy blood production. Include fresh spinach in salads, smoothies, or cooked dishes. (Image: Canva)
7/10

Vitamin C-rich foods: Vitamin C helps in the absorption of iron, which can support healthy platelet production. Eat foods high in vitamin C like oranges, strawberries, kiwi, and bell peppers. (Image: Canva)
8/10

Fenugreek seeds: Fenugreek seeds are thought to have properties that may help increase platelet count. Soak a teaspoon of fenugreek seeds in water overnight and consume them on an empty stomach in the morning. (Image: Canva)
9/10

Aloe vera juice: Aloe vera is believed to support overall health and may aid in maintaining healthy platelet levels. Drink aloe vera juice as directed by a healthcare professional. (Image: Canva)
10/10

Nettle leaf tea: Nettle leaves are known for their potential to support blood health. Brew nettle leaves into tea and drink it regularly. (Image: Canva)
Discover the latest Business News, Budget 2025 News, Sensex, and Nifty updates. Obtain Personal Finance insights, tax queries, and expert opinions on Moneycontrol or download the Moneycontrol App to stay updated!